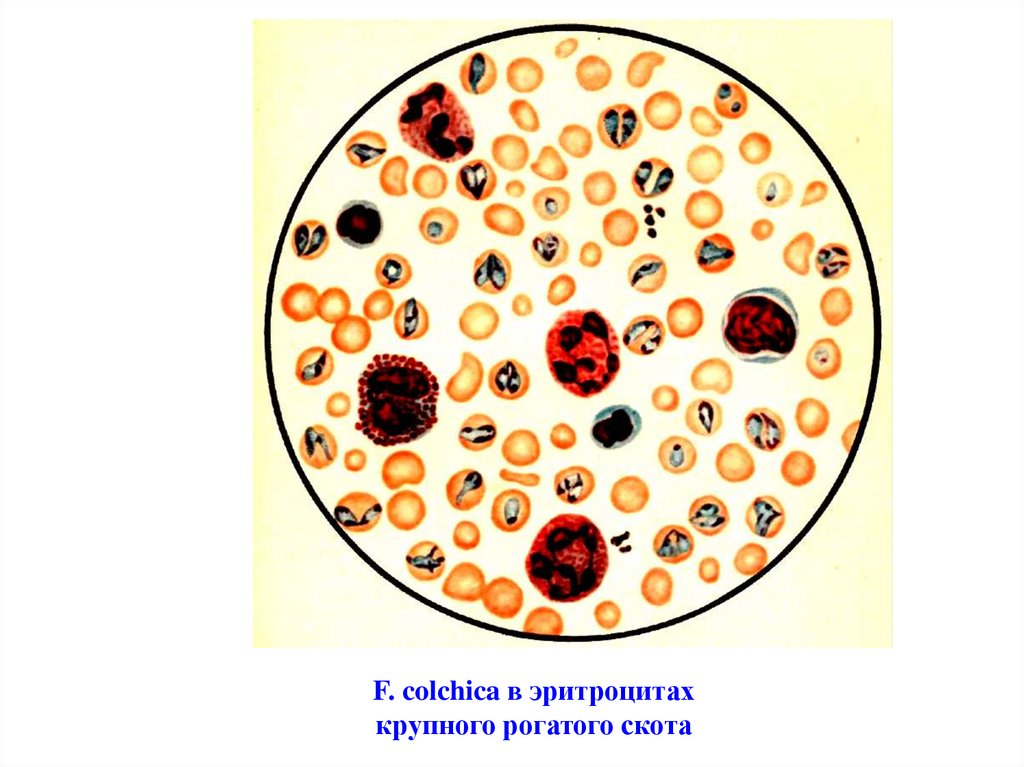

Similar presentations:
Диагностика франсаиеллеза и тейлериоза крупного рогатого скота
1. Практическое занятие на тему: Диагностика франсаиеллеза и тейлериоза крупного рогатого скота
2. Тейлериоз – остро или подостро протекающая трансмиссивная болезнь проявляющаяся увеличением лимфатических узлов, высокой
температурой,анемией, истощением и высоким
процентом смертности.
3.
Этиология. Возбудителямитейлериоза крупного рогатого
скота являются простейшие
Theileria annulata, Th. sergenti,
Th. mutans, Th. оrientalis.
Наиболее патогенными
являются первые два вида.
4. Царство: Животные (Zoa); Подцарство: Одноклеточные или Простейшие (Protozoa); Тип: Простейшие с апикальным комплексом
Царство: Животные (Zoa);Подцарство: Одноклеточные или
Простейшие (Protozoa);
Тип: Простейшие с апикальным
комплексом (Apicomplexa);
Класс: Споровики (Sporozoa);
Отряд: Пироплазмиды Piroplasmida;
Семейство: Тейляриида Theileriidae;
Виды: Theileria annulata, Th. sergenti,
Th. mutans, Th. orientalis.
5. Theileria annulata. Морфологические признаки возбудителей зависят от стадии развития. Размножающиеся в лимфатических узлах
макро - имикромеронты (гранатные тела
или «Коховские шары») имеют
разнообразные формы и размеры
(8-20 мкм).
6. При окраске их по Романовскому цитоплазма окрашивается в голубой цвет, ядро в темно-красный. Ядра макромеронтов имеют крупные
При окраске их по Романовскомуцитоплазма окрашивается в
голубой цвет, ядро в темнокрасный.
Ядра макромеронтов имеют
крупные размеры, неправильную
форму, у микромеронтов они
мелкие, точкообразные.
7. Формы возбудителей тейляриозов
8.
В эритроцитах тейлерииимеют круглую, овальную,
запятовидную,
анаплазмоидную формы.
Величина мерозоитов 0,5-2,5
мкм.
Цитоплазма окрашивается в
голубой, ядро в красный цвет.
9. В одном эритроците может быть 1-7 паразитов, но чаще находятся 2-3 особи, которые преимущественно располагаются в центре.
Пораженность эритроцитовможет доходить до 80-95%.
10.
Биология развития.Клещи, присасываясь к телу
животных и инокулируют
мелкие одноядерные
спорозоиты.
Они проникают в лимфоциты, а с
ними в близлежащий
(регионарный) лимфатический
узел.
11.
Здесь спорозоиты размножаютсяпутем бесполого множественного
деления (мерогония), в
результате чего образуются
многоядерные макромеронты
(гранитные тела, «коховские
шары») с крупными
неправильной формы ядрами.
12.
По мере роста эти макромеронты(гранатные тела) распадаются на
многочисленные мелкие
макромерозоиты, которые
способны проникать в здоровые
лимфоидные клетки.
Процесс мерогонии повторяется
многократно.
13.
На последних стадияхбесполого деления от
вышедших при распаде
гранатных тел мерозоитов
образуются микромеронты,
имеющие мелкие ядра.
14.
В этих микромеронтах путемпочкования образуются
микромерозоиты, которые
проникают в эритроциты.
Размножение паразитов в
эритроцитах продолжается
путем простого деления или
почкования.
15.
16.
Клещи переносчикизаглатывают эритроциты
больного или переболевшего
животного вместе с
микромерозоитами.
17.
Таким образом,эритроцитарные стадии
тейлярий продолжают свое
развитие в кишечнике,
гемолимфе и слюнных
железах личинки, нимфы или
взрослых клещейпереносчиков.
18.
19.
В организме клещейразмножение паразитов
идет половым способом и
из микромеразоитов
образуется инвазионная
стадия тейлярий –
спорозоиты.
20. Эпизоотологические данные В России тейлериоз вызванный Theileria annulata распространен в Ростовской, Астраханской областях и
наСеверном Кавказе, а также
республиках Средней Азии и
на Казахстане.
21.
Тейлериоз крупного рогатогоскота вызванный Theileria
sergenti регистрируется на
Дальнем Востоке и в
Приморском крае, Монголии,
Китае, Корее и Японии.
22.
Переносчиками Th. annulataявляются клещи Hyalomma
anatolicum и др.
Переносчиками Th. sergenti
являются клещи Haemaphisalis
japonica и другие.
23.
Все эти клещитреххозяинные.
Зимуют они в стадии
личинки и нимфы.
Весной имаго клещей,
нападая на животных,
заражает их тейляриозом.
24. Hyalomma anatolicum
25.
26.
Эти виды клещейприспособились к жизни и в
помещениях. Поэтому случаи
тейляриоза встречаются и в
стойловом содержании.
27.
Сезон и динамика тейляриозазависят от климатических
особенностей года, видового
состава переносчиков и от
состояния животных.
28.
Тейлериоз преимущественнонаблюдается летом.
Взрослые животные, особенно
чистопородные, завезенные из
благополучных районов, болеют
очень тяжело, с большим
процентом смертности.
Телята переболевают тейлериозом
тяжелее, чем пироплазмозом.
29.
Патогенез.Патогенное влияние тейлерий
начинается с момента внедрения
в лимфатический узел, что
сопровождается развитием
лимфаденита.
30.
Дальнейшее их размножение ворганах кроветворения
приводит к гибели большого
количества клеточных
элементов.
Разрушение эритроцитов
приводит к развитию анемии.
31.
Увеличение порозности сосудовприводит к отекам и массовым
кровоизлияниям на слизистых
и серозных оболочках
внутренних органов.
Сосудистые расстройства
головного мозга вызывают
повышенную возбудимость, а
затем угнетение.
32.
Интоксикация организмапродуктами жизнедеятельности
тейлярий нарушает функции ЦНС и
процессов пищеварения.
Глубокие морфологические и
функциональные расстройства в
организме животных
сопровождаются развитием тяжелой
клинической картины болезни.
33.
Симптомы болезниПри остром течении болезни,
которое чаще наблюдается у
привозных животных, одним из
первых клинических признаков
является одностороннее увеличение
лимфатических узлов в 2 - 4 раза в
месте укуса иксодового клеща.
34.
Лимфатические узлы становятсяплотными, и болезненными.
Температура тела поднимается до
41-42оС. В этот период в пунктатах из
лимфатических узлов
обнаруживаются гранатные тела, а
на 2-3 -й день после повышения
температуры тела в мазках крови
появляются эритроцитарные формы
тейлярий.
35.
Спустя 3-4 дня после увеличениялимфоузлов теряется апатит,
резко снижается удой. В
дальнейшем развивается атония
преджелудков.
Затрудняется мочеиспускание,
моча выделяется тонкой
струйкой, однако цвет ее остается
в норме.
36.
Видимые слизистые оболочкивначале гиперимированы, затем
анемичны, слабо желтушны, с
множественными
кровоизлияниями.
Появляются кровоизлияния на
коже вымени, мошонки,
внутренней поверхности ушной
раковины, корня хвоста и других
местах.
37.
В период лихорадки у животныхрезко учащается пульс до 100-130
ударов в минуту и дыхание до 4080 движений.
Появляется сухой, прерывистый
кашель, слезотечение (слезы
нередко розового цвета, так как в
них содержатся гранатные тела).
38.
В крови снижается количествоэритроцитов, гемоглобина,
отмечается лейкоцитоз (до 11
тыс. в 1 мм3) , главным образом за
счет лимфоцитов.
Животные стоят, широко
расставив конечности, больше
лежат, поднимаются с большим
трудом. Стельные коровы
абортируют.
39.
Отмечают понос, сменяющийсязапором, животные быстро
худеют, стонут и не реагируют на
внешние раздражители.
Через 6-8 дней после начала
заболевания температура тела
быстро снижается и животное
погибает.
40.
При подостром течении убольных также отмечают
повышение температуры тела.
Но через 2-3 дня она может
снижаться, а затем снова
поднимается и с небольшими
колебаниями держится до конца
болезни.
41.
Через 3-4 дня после началазаболевания животное становится
угнетенным, пропадает аппетит,
снижается удой.
Отмечается анемичность слизистых
оболочек, на них появляются
точечные кровоизлияния.
Наблюдается множественные
кровоизлияния на коже.
42.
Животные быстро худеет, большележит, развивается сердечная
недостаточность.
Многие больные животные
погибают. Особенно высокая
смертность наблюдается среди
привозного скота.
43.
Патологоанатомическиеизменения
Трупы истощены. Видимые
слизистые оболочки бледные, с
желтушным оттенком и
покрыты кровоизлияниями.
Лимфатические узлы увеличены,
на разрезе сочные, с
кровоизлияниями.
44.
Селезенка увеличена в 1,5-2 раза,пульпа размягчена, под капсулой
кровоизлияния.
Печень увеличена, дряблая с
кровоизлияниями под капсулой.
Почки увеличены, с точечными
кровоизлияниями.
45. Гиперплазия селезенки при тейлериозе
46. Кровоизлияния в почке при тейлериозе
47.
Моча прозрачная, наслизистой мочевого пузыря
точечные кровоизлияния.
Книжка заполнена плотными
и сухими кормовыми
массами.
Отмечаются кровоизлияния в
трахее.
48. Кровоизлияния в трахее при тейлериозе
49.
Слизистая оболочка сычугаутолщена, отечна,
гиперемирована, покрыта
точечными или разлитыми
кровоизлияниями и язвами
диаметром 2-12 мм
50. Кровоизлияния, узелки и язвы в сычуге при тейлериозе крупного рогатого скота
51.
Диагноз ставят комплексно сучетом эпизоотологических
данных, клинических
признаков,
патологоанатомических
изменений и лабораторных
исследований.
52.
В начале болезни дляобнаружения гранатных тел
исследуют пунктат из
лимфатических узлов.
Для этого делают мазкиотпечатки и окрашивают по
Романовскому.
53.
В более поздние срокиисследуют мазки крови из
периферических сосудов с
целью выявления
эритроцитарных стадий
тейлярий.
54.
Для ранней диагностикитейлерионосительства
разработаны серологические
реакции (РСК, РДСК, РИФ) с
антигенами, приготовленными
из гранатных тел или из
эритроцитарных форм
тейлерий.
55.
При дифференциальнойдиагностике исключают
пироплазмоз, бабезиоз и
анаплазмоз крупного
рогатого скота.
56.
Лечение.Больных животных отделяют
от стада и представляют им
покой, обеспечивают
легкопереваримыми
кормами и водой.
57.
В рацион включают зеленуютраву или мягкое сено,
измельченные корнеплоды,
отруби или комбикорм,
свежий обрат или цельное
молоко.
58.
Высокоэффективных специфическихпрепаратов нет. Поэтому
рекомендуется несколько схем
лечения:
1. Назначают хиноцид в дозе 1 мг/кг в
сочетании с бигумалем в дозе 12,5
мг/кг. Препараты вводят внутрь в
виде 1%-ного водного раствора,
однократно.
Общий курс лечения до 6 дней.
59.
Одновременно животным даюткофеин, фталазол, сульфат
меди, витамин В12, хлорид
кобальта в соответствии их
инструкциям по применению.
60.
2. Комплексный препарат АБП(акрихин, бигумаль,
плазмацид) назначают в
сочетании с антибиотиками и
симптоматическими
средствами.
АПБ дают внутрь в дозе 1,1 г/кг
живой массы в течение 5-8
суток до снижения
температуры тела.
61.
3. Лечение животных 3-мякомплексами.
В первый комплекс вводят
препараты азидин,
окситетрациклин или
тетрациклин в принятых
дозах.
62.
Спустя 2-6 часов вводятвторой комплекс,
состоящий из 10%-ного
раствора хлорида натрия
и аскорбиновой кислоты
внутривенно, по 100 мл.
63.
При тяжелом состоянииживотного вводят третий
комплекс, состоящий из
40% - ного раствора
глюкозы и 10%-ной
аскорбиновой кислоты, по
200 мл.
64.
Профилактика.Иммунизация животных
против тейлериоза.
Вакцинируют молодняк за
2-3 месяца до выгона на
пастбище.
65.
Вакцину вводят подкожно вдозе 1 мл.
У привитых животных через
14-22 дня может повысится
температура тела и
увеличиваться регионарный
месту введения
лимфатический узел.
66.
Иммунитет наступает на30-35-й день и
сохраняется пожизненно,
если животные ежегодно
подвергается нападению
инвазированных
тейляриями клещами.
67.
Если исключаетсяповторное заражение, то
создается иммунитет
продолжительностью до
двух лет.
68.
ФРАНСАИЕЛЛЕЗКРУПНОГО РОГАТОГО
СКОТА
69. Это остропротекающая кровепаразитарная болезнь, вызываемая возбудителем Francaiella colchica, относящая к семейству Babesiidae,
отрядуPiroplasmida.
Инвазия проявляется высокой
температурой, анемией,
желтушностью, иногда
гемоглобинурией.
70.
• Царство: Животные (Zoa);Подцарство: Одноклеточные или
Простейшие (Protozoa);
Тип: Простейшие с апикальным
комплексом (Apicomplexa);
Класс: Споровики (Sporozoa);
Отряд: Piroplasmida;
Семейство: Babesidae;
Вид: Francaiella colchica
71.
Франсаиеллы в эритроцитахкрови имеют
анаплазмоидные, овальные,
кольцевидные, амебовидные
и грушевидные формы.
При этом грушевидные формы
могут быть одиночными и
парными.
72.
Характерно центральноерасположение паразита в
эритроците, расположение парных
грушевидных форм под тупым
углом, причем каждая группа имеет
почти круглую форму, а вместе они
напоминают оправу очков.
Величина грушевидных форм до 2,8
мкм и как правило, равна радиусу
эритроцита. Зараженность
эритроцитов редко превышает 4-5%
73.
F. colchica в эритроцитахкрупного рогатого скота
74.
БИОЛОГИЯ РАЗВИТИЯВ организм клещей –
специфических переносчиков,
пироплазмиды попадают вместе с
кровью в период кровососания.
В организме клещей паразиты
размножаются путем мерогонии
(множественного деления).
75.
Через гемолимфумерозоиты попавшие из
эритроцитов животных
мигрируют в слюнные
железы и яйцевые
фолликулы клеща.
76.
В отложенных самками такихклещей яйцах находятся
пироплазмиды (бабезии,
пироплазмы, франсаеллы),
которые передаются личинке
трансовариальным путем.
77. Эпизоотология
Восприимчивы все породыскота, буйволы и зебу.
Возбудитель болезни от
больных животных
передается здоровым
однохозяинным клещом
Boophilus calcaratus в стадии
личинки.
78.
ЭпизоотологияВ южных и юго-восточных зонах
бывшего СССР (в Крыму, на
Северном Кавказе, в Закавказье,
Ставропольском, Краснодарском
краях и в Среднеазиатских
республиках) франсаиеллез
встречается чаще пироплазмоза,
и протекает в виде двух или трех
энзоотических вспышек.
79.
Восприимчивы все породы скота,буйволы и зебу. Нередко
франсаиеллез протекает в виде
2-х или 3-х энзоотических
вспышек не редко в смешанной
инвазии с пироплазмозом.
Переносчиками франсаеллеза
крупного рогатого скота
являются клещи: Boophilus
calcaratus в стадии личинки.
80.
Наибольшее количествозаболевших животных
приходится на май-первую
половину июня, затем на июль
– начало августа.
81.
Boophilus calcaratus82.
Местный аборигенный скотболеет легче, чем завезенный
из других регионов и стран.
Старые, истощенные
животные переболевают
тяжелее.
Стельные животные могут
абортировать.
83.
ПатогенезПатологический процесс
развивается в организме
животных по мере размножения
паразитов в кровеносной системе
и накопления продуктов их
жизнедеятельности.
84.
Продукты ихжизнедеятельности влияет на
организм токсически,
вызывая у больного
животного гемолиз
эритроцитов, анемию,
гемолитическую желтуху и
гемоглобинурию.
85.
Симптомы болезниИнкубационный период при
заражении через клещей длится
9–15 сут. Заболевание начинается
с резкого подъема температуры
тела, до 41–42° С. С повышением
температуры у коров резко
снижаются удои, в последующем
молокоотдача полностью
прекращается.
86.
У больного животного пропадаетаппетит, прекращается жвачка,
они больше лежат, поднимаются с
трудом, быстро худеют. В начале
болезни перистальтика
кишечника усилена, кал
становится сухим, со слизью, у
животного развивается стойкая
атония преджелудков.
87.
Видимые слизистые оболочки вначале болезни анемичные, в
дальнейшем желтушные. На
слизистой оболочке
конъюнктивы и влагалища
наблюдаются точечные
кровоизлияния. Пульс до 100–
120 ударов в мин, сердечный
толчок усилен. Дыхание
учащается до 30–50 в одну мин.
88.
Гемоглобинурия бывает реже, хотяданная инвазия протекает тяжелее.
Во время мочеиспускания животное
сильно тужится, моча выделяется
небольшими прерывистыми
порциями. Стельные коровы
абортируют. У тяжелобольных
животных может быть
фибриллярное сокращение
отдельных мышц; животные стонут,
скрежещут зубами и погибают.
89.
Патологоанатомическиеизменения
Труп истощен. Слизистые оболочки
анемичны и слегка желтушны.
Подкожная клетчатка, серозные
покровы, сухожилия, фасции и
сальник желтушны. На трупе резко
выражены явления
геморрагического диатеза. На
слизистых и серозных оболочках
наблюдаются кровоизлияния.
90.
Лимфатические узлы увеличены, наразрезе сочные, иногда с
кровоизлияниями в паренхиме. В
грудной, брюшной полостях, и
сердечной сорочке отмечается
значительное количество жидкости.
Сердце увеличено в объеме, дряблое,
с точечными и диффузными
кровоизлияниями под эпикардом и
эндокардом. Кровь водянистая и
плохо свертывается. Селезенка
увеличена, пульпа размягчена, с
кровоизлияниями под капсулой.
91.
Печень увеличена, дряблая,глинистого цвета. Желчный пузырь
переполнен темно-зеленоватой
желчью, нередко кашицеобразной
консистенции. Почки
гиперемированы, темно-вишневого
цвета, под капсулой кровоизлияния,
граница между корковым и
мозговым слоями стерта. Мочевой
пузырь растянут, переполнен мочой
красного цвета. Слизистые
оболочки сычуга и тонкого отдела
кишечника катарально воспалены с
точечными или разлитыми
кровоизлияниями.
92.
Диагнозставят комплексно, с учетом
эпизоотологических данных
(наличие клещейпереносчиков, были ли
заболевания в прошлом,
сезонность болезни).
93.
Учитывают такжеклинических признаков
болезни,
патологоанатомических
изменений, с обязательным
исследованием мазков
крови (окраска по
Романовскому - Гимза).
94.
При взятии мазков крови следуетиметь то, что при франсаиеллезе
паразиты в крови появляются
лишь на 4-5–й день после
подъема температуры тела. В
первые дни болезни паразитов
можно обнаружить в мазках из
пунктата лимфатических узлов
и паренхиматозных органов
95.
Лечебно-профилактическиемероприятия проводятся
также как и при
пироплазмидозах крупного
рогатого скота

medicine
medicine








